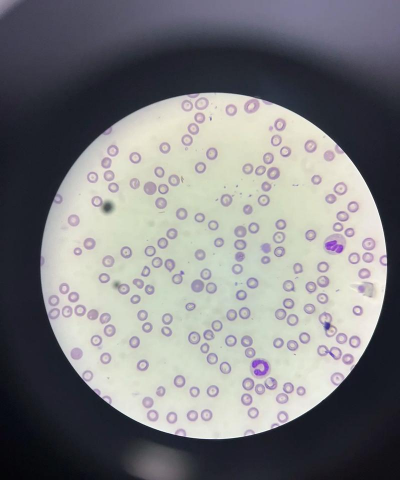
昆明花卉批发，货源渠道多，价格优势大

草莓栽培技术
草莓为多年生草本植物,原产自南美,中国各地以及欧洲等地广为栽培。草莓的品种很多,全国共有20000多个,但大面积栽培的优良品种只有几十个。草莓喜温凉气候,有较强的的耐荫性。草莓的营养价值丰富,被誉为“水果皇后”。那么,草莓栽培技术是什么呢?一起来看看吧!
草莓栽培技术
1、选地整地
草莓园应选光照充足,地势稍高、地面平坦、灌排方便、土壤肥沃疏松。前茬作物为豆类或葱蒜类蔬菜地为宜,园地应先行除杂草、灭地下害虫。可用50%辛硫磷乳油1000倍液喷洒湿润土层5-6厘米),防治蛴螬、蝼蛄、地老虎。1周后,根据种植的数量适当施肥,结合深翻园地,精细整地,做成高20厘米,宽50厘米的畦面,畦沟宽30厘米。
2、选草莓苗
做好草莓幼苗的选择,尽量选择一些比较好的幼苗,最好选择一些当面就可以开花结果的草莓幼苗,最好草莓的幼苗带着一些根系或者尽量多带一些草莓幼芽或者草莓叶子。
3、选择种植时间
草莓的种植季节的选择,最好选择在春季,或者初春,或者春末夏初,或者清明前后种植,这些季节或者时令都比较适合种植。
4、灌排方法
在开花与浆果生长初期,分别灌水1次。宜用沟灌,使水灌到沟高2/3处为好,让水渐渐渗入畦土,沟内余水排出。若天旱,应5-7天灌水1次。草莓是喜大水大肥的植物,但是用不同的泥土有不同的浇水法,比如我养花,大多是用山土调配,有点点的粘性,表面干结就会出现丝丝的裂缝,说明就要浇水了。
5、加盖塑膜
地膜覆盖有显著的早熟、增产效果,还能提高果实质量,增加商品果率。一般在3月中下旬开始盖膜。注意盖膜前一定要摘除植株上的枯叶、老叶。
6、通风操作
草莓苗生长的土壤湿度应在70%-80%为宜。棚内空气湿度以60%--70%为好。因此,当棚内气温超过30℃时,应通风。11月至12月应于上午10时至下午3时揭开大棚及中棚两头塑膜通风。当棚内湿度超过70%时,也应通风,以降低棚内空气湿度。花期棚内放养蜜蜂,可在大、中棚两头另做尼龙丝网,便于顺利通风。大棚通风的另一作用,是防治草莓白粉病。
7、采收
草莓苗开花、坐果到浆果着色,软化,释放特有香味,时间约30天。草莓浆果成熟后,应分批采收上市。一般亩产草莓1500千克。
草莓种植的注意事项
1、草莓种植过程中要注意避免连作和重茬,以减少病虫害的发生和传播。
2、在施肥时应避免过量使用氮肥,以免导致草莓植株生长过旺而果实品质下降。
3、在浇水时应注意控制水量和水质,避免造成土壤过湿或水质污染等问题。
4、在病虫害防治方面应坚持预防为主、综合防治的原则,合理使用农药和生物防治手段,以减少对环境和人体的危害。
5、在采收和储存过程中要注意保持草莓的完整性和新鲜度,避免造成损失和浪费。
葱叶里面虫子怎么治疗
在葱的生长过程中,有时会遇到叶片内出现虫子的情况。这些虫子不仅会损害葱的外观,还可能影响其健康生长,最终导致减产。葱叶内的虫子主要是一些食叶昆虫的幼虫,如葱蝇幼虫等。一旦发现葱叶内有虫子,应及时采取措施进行防治,以避免虫害扩散并对葱的生长造
· 2025-11-05

蔬菜四个种植方法
蔬菜长得好不好,从一开始种植就决定了,种植方法决定了是否出苗快、出苗齐,长势健壮。不管什么蔬菜,只要一开始秧苗长得好,中后期才能长势茂盛,管理起来也很轻松,如果秧苗长得不好,出苗不齐、出现断苗、缺苗等,到了中后期想让其长好可就难了。那么,蔬
· 2025-11-05

藕种植时间和方法
藕属于睡莲科多年生水生宿根草本植物,是一种重要的水生蔬菜,具有很高的经济价值。它用途广泛,营养丰富,供应期长,既可以生食也可以熟食,是冬春季节及淡季重要的蔬菜之一。那么,藕的种植时间是什么时候?种植方法又是怎样的呢?接下来,让我们一起了解一
· 2025-11-05

蚊子的品种
蚊子属于昆虫纲、双翅目、蚊科,是自然界中广泛存在的一类昆虫。全球范围内已知的蚊子种类超过了3,000种,其中有一些特定种类与人类的生活密切相关,并且能够传播各种疾病。那么,蚊子的品种有哪些呢?一起来看看吧!蚊子的品种1、库蚊、库蚊是最常见的
· 2025-11-05

蚕的生长过程
蚕,又称家蚕,或习称蚕。一种具有很高经济价值的吐丝昆虫。以桑叶为食料,茧可缫丝,丝是珍贵的纺织原料,主要用于织绸,是优良的纺织原料,在军工、交电等方面也有广泛用途。蚕的蛹、蛾和蚕粪也可以综合利用,是多种化工和医药工业的原料,也可以作植物的养
· 2025-11-05

蚯蚓吃什么 如何喂养
蚯蚓的生活习性非常独特。它们通常生活在土壤中,白天休息,晚上活动。蚯蚓的身体柔软而长,没有眼睛和触角,但它们可以通过感觉器官来感知周围的环境。蚯蚓的身体表面覆盖着一层粘液,这有助于它们在土壤中移动。那么,蚯蚓吃什么?如何喂养呢?蚯蚓吃什么1
· 2025-11-05

蛇果为什么叫蛇果
蛇果是苹果的一种,其属于蛇果类,所以称为蛇果。蛇果的肉质非常丰盛,质脆,味道甘甜,果汁丰富,不仅含有丰富的果糖、葡萄糖还有很多的维生素C,常吃蛇果有利于肌肤美白、水润充盈。蛇果的形态特征蛇果,蔷薇科苹果属的多年生落叶乔木植物。蛇果果实大,圆
· 2025-11-05

梅花什么时候来开
梅花的花期因品种、气候和地理位置的不同而有所差异,主要集中在冬季末至春季初。以下是综合各地信息的详细分析:总体花期:梅花通常在12月至次年3月开放,部分品种可持续到4月甚至5月。早花品种:如朱砂梅、绿萼梅等,可能在12月或1月开花。晚花品种
· 2025-11-05

狗的红细胞
红细胞的主要功能是将氧气输送到身体各组织,以满足细胞代谢的需求。氧气分子附着在血红蛋白上,这是一种含铁的蛋白质,位于红细胞内部,赋予细胞红色。氧气从肺部被携带并通过红细胞内的血红蛋白输送到全身组织。细胞利用氧气产生能量。在此过程中,会产生二
· 2025-11-05
云松的养殖方法和注意事项
云松又叫云竹,云片草,以盆栽观叶为主,又为重要切叶材料,为多年生草本植物,云松古时多为隐居者视作伴侣,姿态翠丽清雅,极富诗情画意,是观赏价值较高的树种。那么,云松的养殖方法和注意事项有哪些呢?下面,我们一起来了解一下吧!云松的养殖方法1、土
· 2025-11-05







